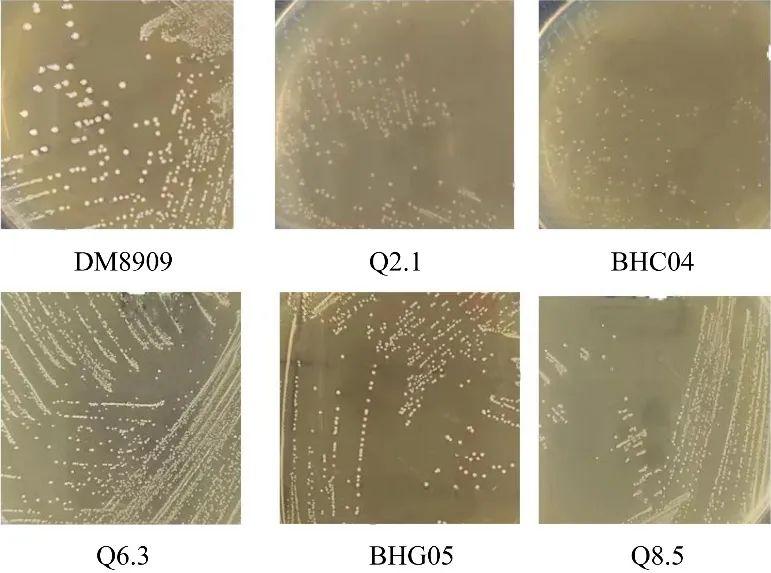

靶向妇科炎症:两株阴道乳杆菌的筛选、抑菌机制与益生潜力分析(二)
2结果与分析
2.1菌株分离结果
采用微生物传统分离方法,用MRS培养基从阴道样品中初步分离出5株疑似乳杆菌的菌株。对照菌株DM8909和5株分离菌株的菌落形态如图1所示,对照菌株DM8909的菌落为乳白色,表面光滑、隆起,边缘整齐,易挑起。Q2.1、BHC04和Q8.5的菌落为白色,表面干燥无光泽,扁平,边缘整齐,不易挑起。Q6.3和BHG05的菌落为乳白色,表面光滑、隆起,边缘整齐,易挑起。6株菌株的菌体形态如图2所示,对照菌株DM8909的菌落的菌体为较粗的杆状,Q2.1、BHC04和Q8.5的菌体为细长的杆状,Q6.3和BHG05的菌体为短杆状。
图1乳杆菌的菌落形态

图2乳杆菌的菌体形态(100×)
2.2菌株的16S rRNA基因鉴定
将16S rRNA基因鉴定结果在NCBI网站进行BLAST同源性对比,DM8909为德氏乳杆菌,Q2.1、BHC04和Q8.5为卷曲乳杆菌,Q6.3和BHG05为格氏乳杆菌。
2.3乳杆菌的生长特性
菌株的生长曲线如图3所示,0−4 h时为菌株生长的延滞期,但菌株Q2.1、BHC04和BHG05增长较快,这3株乳杆菌延滞期较短,可见其适应环境能力强,4−12 h为对数生长期,除Q8.5外,各菌株迅速增长,20 h时除Q8.5外,其余菌株均已进入稳定生长期,Q8.5的对数生长期较长,在32 h基本稳定。在相同培养时间内,菌株BHC04和Q6.3的生长繁殖能力最强,最终菌液浓度最高。
乳杆菌培养液pH值变化与菌株的生长情况密切相关。菌株的生长曲线如图4所示,0−20 h pH随着菌体数目的增加而快速降低,24 h后随着培养时间的延长,导致代谢产物积累和营养物质消耗,使待测菌株的增殖速度受到明显抑制,pH值的下降速率减缓。在48 h时,比较发现BHG05、Q6.3和Q8.5的产酸能力较强,最终pH分别为3.90、3.80和4.03。

图3乳杆菌的生长曲线

图4乳杆菌的产酸曲线
2.4菌株的黏附能力评价
2.4.1菌株的疏水能力
菌体表面的疏水性与黏附能力呈正相关关系,因此疏水能力常常用来评价乳杆菌的黏附性能。如图5所示,5株乳杆菌的表面疏水能力均显著高于对照菌株DM8909,说明5株菌均具有较强的疏水能力。卷曲乳杆菌BHC04和Q8.5的疏水能力最强,分别为94.26%和90.72%。另外发现,卷曲乳杆菌Q2.1、BHC04和Q8.5的疏水能力均在85.00%以上,格氏乳杆菌Q6.3和BHG05的疏水能力也无显著性差异,3株卷曲乳杆菌的疏水能力均显著高于2株格氏乳杆菌,这表明相同菌种的表面疏水能力可能相似,即菌株的疏水能力与菌种有关,由研究结果可以发现卷曲乳杆菌具有较强的表面疏水能力。

图5乳杆菌的疏水能力
2.4.2菌株的自凝集率
菌株的自凝集率如图6所示,6株菌的自凝集率均在40.00%以上,卷曲乳杆菌Q2.1、BHC04和Q8.5的自凝集率显著高于对照菌株,分别为75.75%、78.95%和87.99%。格氏乳杆菌BHG05的自凝集率为53.37%,显著高于对照菌株,格氏乳杆菌Q6.3的自凝集率为43.86%,显著低于对照菌株(DM8909为50.69%)。3株卷曲乳杆菌的自凝集率均显著高于2株格氏乳杆菌,因此可以推测菌株的自凝集率也与菌种有关,卷曲乳杆菌具有较强的自凝集率。

图6乳杆菌的自凝集率
2.4.3乳杆菌和致病菌的共凝集率
与大肠杆菌的共凝集率见图7A,卷曲乳杆菌Q2.1、BHC04和Q8.5的与大肠杆菌的共凝集率显著高于对照菌株,分别为58.24%、61.38%和69.11%。格氏乳杆菌BHG05与大肠杆菌的共凝集率为18.41%,显著高于对照菌株,Q6.3与大肠杆菌的共凝集率与对照菌株无显著性差异。与金黄色葡萄球菌的共凝集率见图7B,卷曲乳杆菌Q2.1、BHC04和Q8.5的与金黄色葡萄球菌的共凝集率显著高于对照菌株,分别为54.48%、56.43%和63.67%。格氏乳杆菌Q6.3和BHG05与金黄色葡萄球菌的共凝集率与对照菌株存在显著性差异,分别为17.27%和18.17%。与白假丝酵母的共凝集率见图7C,卷曲乳杆菌Q2.1、BHC04和Q8.5与白假丝酵母的共凝集率显著高于对照菌株,分别49.88%、67.21%和60.22%。格氏乳杆菌BHG05和Q6.3与白假丝酵母的共凝集率为21.14%和14.21%,显著高于对照菌株。3株卷曲乳杆菌与致病菌的共凝集率均显著高于2株格氏乳杆菌,可以推测菌株的共凝集率也与菌种有关,卷曲乳杆菌具有较强的共凝集率。综上所述,乳杆菌Q2.1、BHC04、Q8.5和BHG05均具有较强的黏附能力,而且黏附能力与乳杆菌种类有关,卷曲乳杆菌具有更强的黏附能力。

图7乳杆菌与大肠杆菌(A)、金黄色葡萄球菌(B)和白假丝酵母(C)的共凝集率
2.5对大肠杆菌和金黄色葡萄球菌的抑制能力

表1 CFS对大肠杆菌和金黄色葡萄球菌的抑制能力
选取DM8908为阳性对照菌株,以乳酸链球菌素(nisin)为阳性对照,用牛津杯法以大肠杆菌和金黄色葡萄球菌为指示菌评价筛选菌株的抑菌能力。结果如表1所示,对大肠杆菌抑制能力较强的菌株依次为Q8.5(25.00±2.18)mm、BHG05(23.67±1.76)mm、BHC04(23.50±1.50)mm、Q2.1(21.83±2.02)mm和Q6.3(21.00±0.50)mm。对金黄色葡萄球菌抑制能力较强的菌株依次BHC04(26.00±2.65)mm、Q6.3(25.67±1.53)mm、BHG05(25.00±1.00)mm、Q2.1(23.67±3.21)mm和Q8.5(22.17±2.02)mm。这5株菌产生抑菌圈的大小均在20.00 mm以上,其中BHC04、BHG05和Q8.5对大肠杆菌的抑制能力与对照菌株DM8909存在显著性差异,5株菌对大肠杆菌和金黄色葡萄球菌的抑制能力显著高于阳性对照乳酸链球菌素。由图8可知,5株菌对大肠杆菌产生的抑菌圈透明且明显大于乳酸链球菌素,说明其抑菌潜力巨大。另外研究发现,这5株菌的CFS的pH均可达到pH 4.00以下,推测其抑菌能力可能与发酵液pH存在某种联系。

图8 CFS对大肠杆菌和金黄色葡萄球菌产生的抑菌圈
相关新闻推荐
1、临床结核分枝杆菌体外药敏试验:分子DST检测VS表型DST药敏诊断技术(一)
